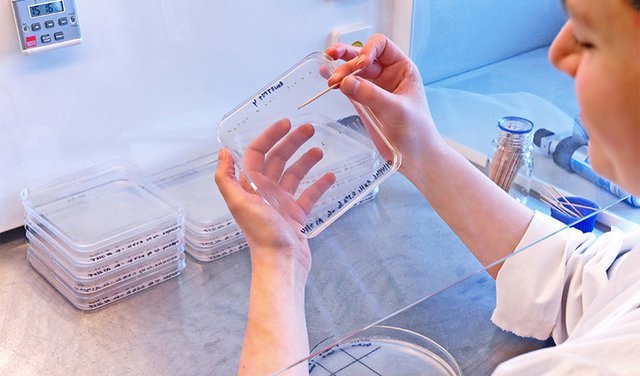

Evolution im Zeitraffer durch alternative Chromosomen-Organisation
Forschende haben tiefgreifende Auswirkungen einer atypischen Organisation von Chromosomen auf die Genomorganisation und Evolution aufgedeckt. Ihre Ergebnisse schildert das Team unter der Leitung von André Marques vom Max-Planck-Institut für Pflanzenzüchtungsforschung in Köln (MPIPZ) jetzt in der Zeitschrift Cell. Unsere Studie zeigt, so Marques, "dass der Übergang zu einer holozentrischen Chromosomenarchitektur die Art und Weise, wie Genome organisiert und reguliert werden, stark beeinflusst hat und dass sich Genome durch die Verschmelzung ihrer Chromosomen schnell weiterentwickeln können". Die Ergebnisse zeigen vielversprechende Ansätze für die Pflanzenzüchtung, die in der Regel auf die Fähigkeit angewiesen ist, Gene zwischen Chromosomen und Organismen auszutauschen. "Holozentrische Pflanzen ermöglichen den Austausch von Genen in der Nähe der Zentromere, was bei monozentrischen Arten normalerweise unterdrückt wird. Wenn wir verstehen, wie holozentrische Pflanzen dies tun, könnten wir diese Gene in monozentrischen Arten „freischalten“ und sie für die Züchtung von leistungsfähigeren, widerstandsfähigeren Pflanzenarten zugänglich machen."
Quelle: MPIPZ